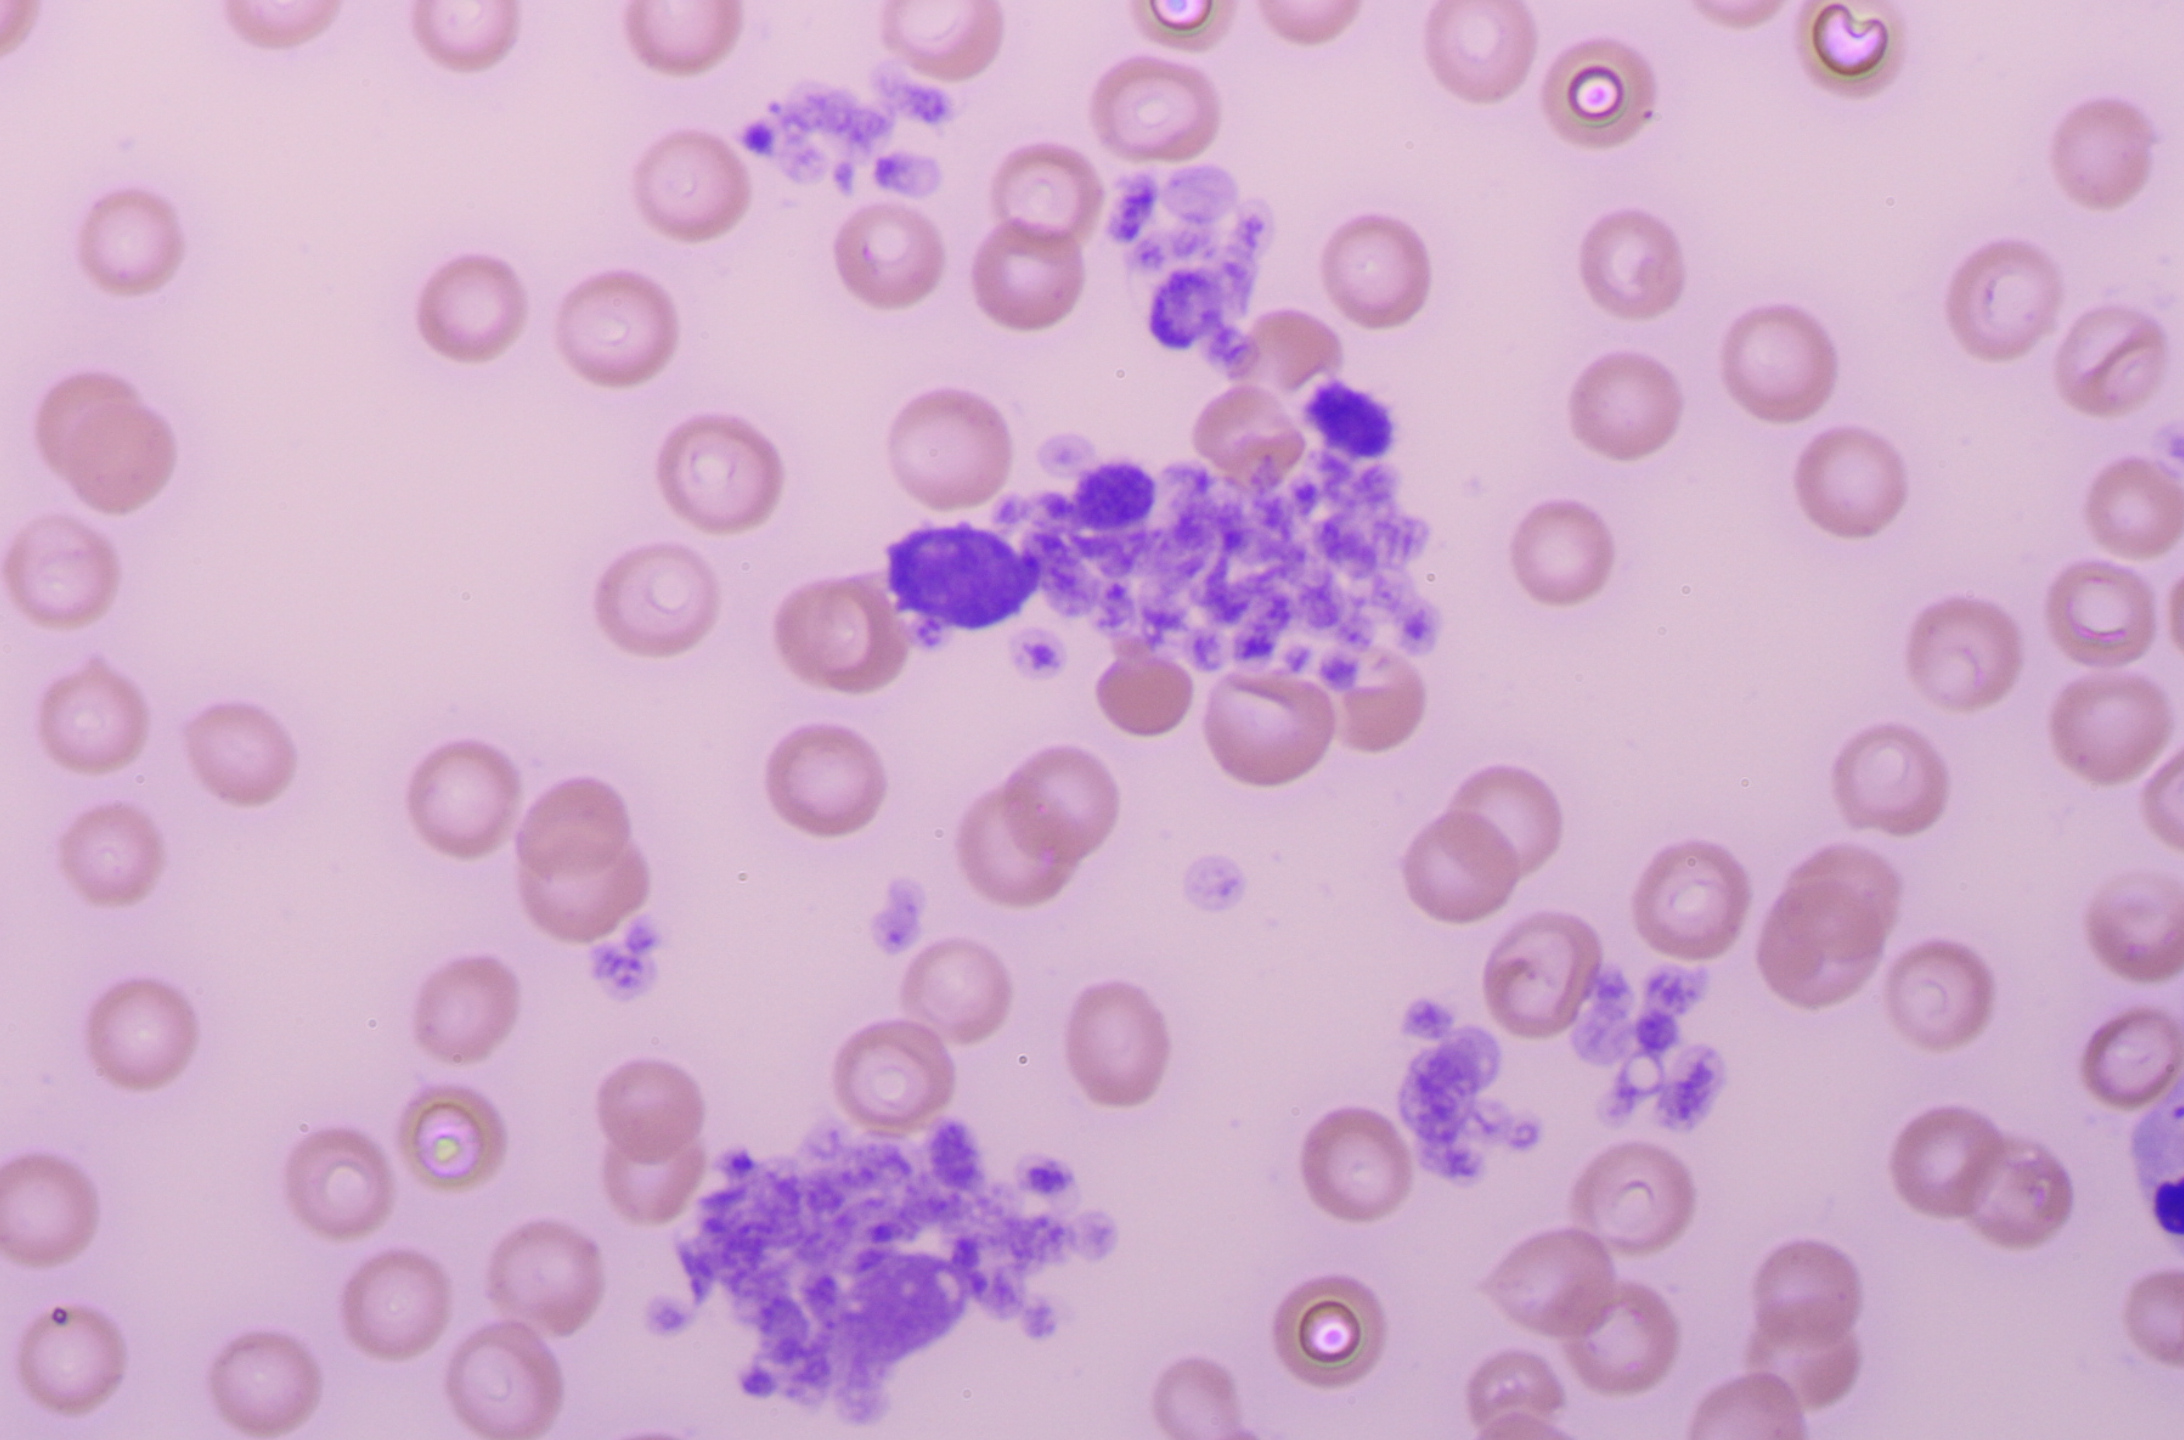

2026/02/10
巨大血小板の法則
埼玉県ふじみ野市の大井みどり動物病院です。
イヌやネコの血液検査で「巨大血小板」が認められることがあります。これは通常の血小板より明らかにサイズが大きい血小板のことですが、血液の標本を作り、顕微鏡で確認しないとわかりません。
血小板は主に出血を止める役割を担っていますが、それだけではありません。血管内皮の修復を助けたり、炎症反応に関わったり、免疫応答の一部を担ったりもします。数が極端に少ないと止血能力が低下して皮膚にあざができたり、鼻血・歯茎出血・血尿・血便が出やすくなるほか、感染に対する抵抗力が落ちたり、炎症がコントロールしにくくなったりするケースもあります。
巨大血小板には、「正常」な場合と「異常」な場合があります。
イヌでは特にキャバリアなどで巨大血小板が多く見られ、30〜50%程度の個体にこの特徴があります。原因は生まれつきの遺伝子変異によるものです。
この遺伝性のケースでは、実際には問題がほとんどありません。なぜなら、血小板の能力は「個数」ではなく「全体の総体積」で決まるからです。巨大血小板は通常の2〜4倍の大きさがあるため、数が少なくても総体積が正常です。十分に働きます。
一方、遺伝性以外の巨大血小板もありますが、これは血小板が急激に壊されたり消費されたりする深刻な状態で、骨髄が緊急に若い血小板を大量に作っている状態です。
若い血小板はサイズが大きくなるため、巨大血小板が目立つようになります。イヌ・ネコともに、このパターンは注意が必要で、背景に重い病気が隠れている可能性が高いのです。
その出現が認められる代表的な疾患には、犬の免疫介在性血小板減少症があります。
重度の感染症では、全身に炎症が広がり、血小板が大量に使われることでも出現します。
腫瘍、敗血症、急性膵炎から播種性血管内凝固症候群(DIC)が生じ、全身の凝固が乱れ、血小板が消費され巨大血小板が出現することもあります。
悪性腫瘍でも二次的に血小板減少を起こし、巨大血小板が出現することがあります。
これらのケースでは、なにかしらの症状が伴うことがほとんどです。
つまり、巨大血小板は、遺伝的に見られる無症状・良性のケースが代表的ですが、それ以外の状況で巨大血小板が確認されたら、上記のような重病が示唆され、体が深刻な問題に直面している可能性があります。
したがって、臨床現場では、血塗抹標本で巨大血小板を丁寧に確認することが重要なのです。血塗抹で巨大血小板を見つけたら重い病気を強く疑い、早急に原因を探る必要があります。
ようするに、犬猫で「具合が悪い場合に、巨大血小板が見つかったら、レッドフラッグサイン」なのです。
例えば、健康診断としての血液検査で、巨大血小板が見つかってもそれは、遺伝性の可能性が非常に高いが、低体調の時にそれが見つかったら、重病の可能性を示唆します。
この法則は臨床では非常に有用なのです。しかし、それをそのままの形で述べている獣医臨床の教科書や論文はおそらくありませんが、理論的に導かれます。
巨大血小板があるかどうかは、血液の標本を普段から見ていないと気づきにくいでしょう。血小板は小さく、みようとしないと見逃すことが多いですので、そこが面白いところでもあります。
また、血小板を染色するのもすこしコツがいりますし、小さい割に白血球のようにいろいろな形が変化に富むところも興味深い点です。
それから、血小板は骨髄内で作られます。ET(本態性血小板血症)という血小板を異常にたくさん作ってしまう腫瘍があるのですが、以前疑い骨髄検査をしたが違ったことがあります。ETは一生に一度診察するかどうかの病気かもしれませんが、血小板をいつも確認していないと見逃すでしょう。
ちなみに画像は、蛋白喪失性腸症という病気のイヌの血小板です。
受付時間
| 受付時間 | 月 | 火 | 水 | 木 | 金 | 土 | 日祝 |
|---|---|---|---|---|---|---|---|
| 9:50-12:45 | ○ | ○ | 休 | ○ | ○ | ○ | ○ |
| 15:50-18:30 | ○ | ○ | 休 | ○ | ○ | ○ | ○ |
水曜休診
夏季休業なし
12月30日から1月3日休診

